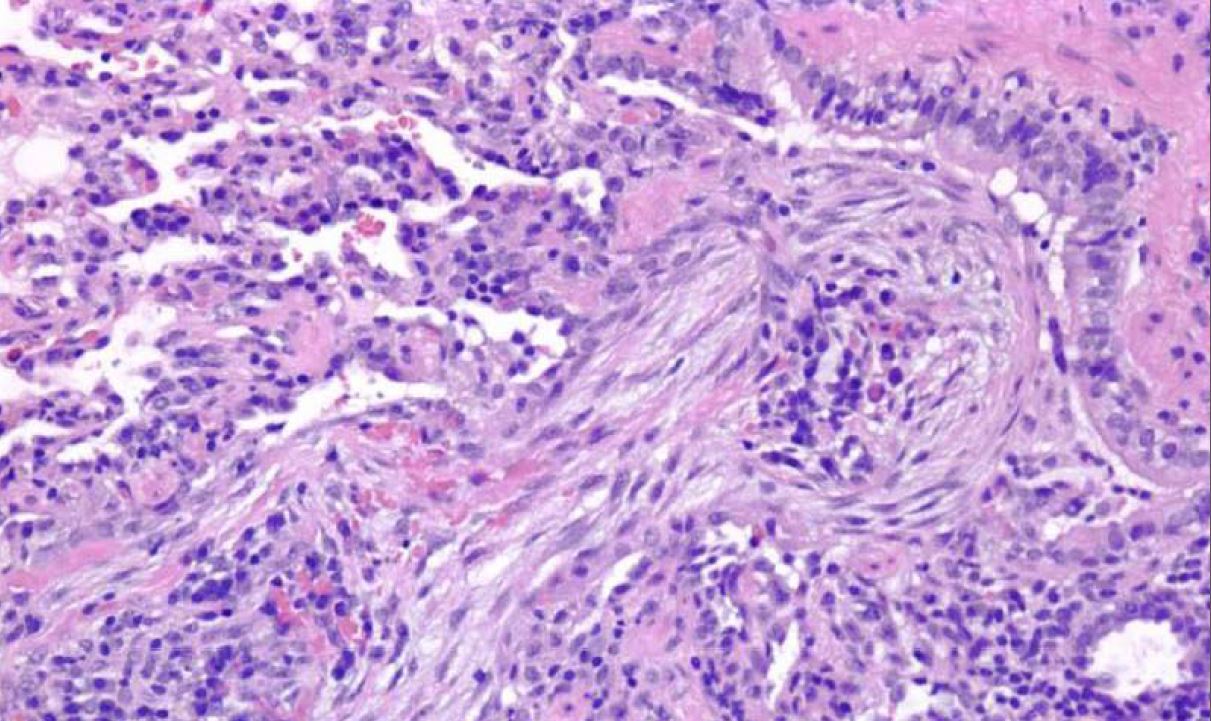

What are the etiologies of obliterative bronchiolitis?

– Chronic airway rejection (lung transplant)
– GVHD (bone marrow transplant)
– Infection (Adenovirus)
– Drugs
– Connective tissue disease
What are the differences between organizing pneumonia (formerly BOOP) and obliterative bronchiolitis?
HISTOLOGY: org PNA has airspace filling fibroblastic plugs whereas ob bronch has submucosal scars
LOCALIZATION: org PNA involves peribronchiolar alveoli and bronchiles whereas ob bronch is localized to the bronchioles
PFTs: org PNA is RESTRICTIVE whereas ob bronch is OBSTRUCTIVE
What is the most common AIDS defining lesion in children?
Lymphoid Interstitial Pneumonia (LIP)

What process is shown here?

Centrilobular emphysema
What process is shown here?

Panacinar emphysema
What infectious etiology is being shown?

Coccidioides
The black structures are spherules, some ruptured and some intact. The intact ones contain endospores and when ruptured you can see free endospores.
This lesion in the lung is seen more commonly in women with an average age in the 40s and shows papillary like projections lined by epithelioid cells with a central proliferation of polygonal mesenchymal appearing cells. Both populations are TTF1 positive indicating type II pneumocyte origin for this tumor.

Sclerosing hemangioma of the lung
What process is being shown here?
Hallmarks are lower lobes and peripheral/paraseptal
accentuation of changes

UIP

Patients with pulmonary Langerhans cell histocytosis almost always have what history?
SMOKING
What is the definition of minimally invasive lung adenCA?
< 3 cm lepidic predominant < 5 mm invasion
What lesion is this?
Localized proliferation of mild to moderately atypical cells lining involved alveoli and sometimes respiratory bronchiols and usually less than 5 mm in diameter.

Atypical Adenomatous Hyperplasia
Name this lesion.

Respiratory Bronchiolitis
Name this entity.

NSIP
Name this entity.
Organizing pneumonia

Name this entity.

UIP

Name this entity.

Organizing diffuse alveolar damage
notice hyaline membrane
Name this entity.

NSIP
Name this entity.

UIP
Name this entity.

NSIP
Name this entity.

Desquamative Interstitial Pneumonia
What is being shown here?

Pleural bleb in emphysema

What are the associations of lymphoid/lymphocytic interstitial pneumonia?

Overlapping features with diffuse nodular lymphoid hyperplasia (DLH), dense diffuse interstitial lymphoid infiltrates and follicular bronchiolitis
Associations:
Autoimmune diseases- especially connective tissue
Immunodeficiency syndromes–congenital and acquired
Drug reactions
Bone marrow transplantation

What is this entity and what is your differential?

Capillaritis
Evidence of diffuse pulmonary hemorrhage
DDX: Goodpasture, Microscopic polyangiitis, Lupus, Wegener’s, mixed cryoglobulinemia, Henoch-Schonlein purpura and antiphospholipid syndrome
If you see a lung tumor with this appearance, what is diagnose?

Pulmonary blastoma (fetal adenocarcinoma)
Primitive glands and stroma, resembles fetal lung




